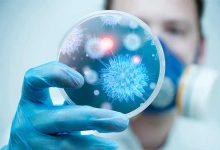
بیماری های عفونی و مقابله با انها

شناخت انواع، علائم و درمانهای موجود آرتریت

انواع آرتریت
آرتریت به گروهی از بیماریها اشاره دارد که باعث التهاب و درد در مفاصل میشوند. از جمله شایعترین انواع آرتریت میتوان به آرتروز، آرتریت روماتوئید، آرتریت پسوریاتیک، نقرس و آرتریت عفونی اشاره کرد. هر یک از این انواع ویژگیها و علائم خاص خود را دارند.
آرتروز (استئوآرتریت) شایعترین نوع آرتریت است که عمدتاً در اثر فرسایش و تخریب غضروف مفاصل ایجاد میشود. این بیماری بیشتر در افراد مسن رخ میدهد و مفاصل بزرگ مانند زانوها، رانها و دستها را تحت تأثیر قرار میدهد.
آرتریت روماتوئید یک بیماری خودایمنی است که سیستم ایمنی بدن به اشتباه به بافتهای مفصلی حمله میکند و باعث التهاب و آسیب مفاصل میشود. این بیماری میتواند مفاصل کوچک دست و پا را تحت تأثیر قرار دهد و به تدریج باعث تخریب مفاصل شود.
آرتریت پسوریاتیک در افرادی که به پسوریازیس مبتلا هستند، رخ میدهد. این نوع آرتریت میتواند باعث التهاب و درد در مفاصل شود و ممکن است همراه با علائم پوستی پسوریازیس باشد.
نقرس به دلیل تجمع کریستالهای اسید اوریک در مفاصل ایجاد میشود و میتواند باعث درد شدید و ناگهانی در مفاصل شود. این بیماری معمولاً مفاصل پاها، بهویژه انگشت بزرگ پا را تحت تأثیر قرار میدهد.
آرتریت عفونی در اثر عفونتهای باکتریایی، ویروسی یا قارچی در مفاصل ایجاد میشود. این نوع آرتریت میتواند باعث التهاب شدید و درد در مفاصل شود و نیازمند درمان فوری است.
علائم آرتریت
علائم آرتریت ممکن است بسته به نوع و شدت بیماری متفاوت باشد، اما علائم شایع شامل درد مفاصل، تورم، سفتی و کاهش حرکت مفاصل است. برخی از انواع آرتریت ممکن است علائم سیستمیک مانند تب، خستگی و کاهش وزن را نیز نشان دهند.
درد مفاصل یکی از علائم اصلی آرتریت است که ممکن است به صورت مداوم یا دورهای رخ دهد. این درد معمولاً با فعالیتهای بدنی افزایش مییابد و در حالت استراحت کاهش مییابد.
تورم مفاصل در اثر التهاب ناشی از آرتریت رخ میدهد و میتواند باعث محدودیت حرکت و ناراحتی در مفاصل شود.
سفتی مفاصل، بهویژه پس از استراحت طولانی یا در صبحها، از دیگر علائم شایع آرتریت است. این سفتی ممکن است باعث مشکلاتی در انجام فعالیتهای روزمره شود.
کاهش حرکت مفاصل نیز از علائم آرتریت است که میتواند به تدریج پیشرفت کند و انجام کارهای سادهای مانند بالا بردن دستها یا راه رفتن را دشوار کند.
تشخیص آرتریت
تشخیص آرتریت نیازمند بررسی دقیق تاریخچه پزشکی بیمار، معاینه فیزیکی و انجام آزمونهای تشخیصی است. پزشکان معمولاً از روشهای تصویربرداری مانند رادیوگرافی، MRI و اولتراسونوگرافی برای بررسی وضعیت مفاصل استفاده میکنند. همچنین، آزمونهای خونی میتوانند به شناسایی عوامل التهابی و خودایمنی کمک کنند.
معاینه فیزیکی شامل بررسی مفاصل برای تشخیص تورم، سفتی و درد است. پزشک همچنین ممکن است دامنه حرکت مفاصل را ارزیابی کند.
آزمونهای تصویربرداری مانند رادیوگرافی، MRI و اولتراسونوگرافی میتوانند به شناسایی آسیبهای مفصلی، تجمع مایعات و تغییرات ساختاری مفاصل کمک کنند.
آزمونهای خونی میتوانند به شناسایی علائم التهابی مانند افزایش سطح CRP و ESR و همچنین عوامل خودایمنی مانند فاکتور روماتوئید و آنتیبادیهای ضد هستهای کمک کنند.
درمانهای موجود
درمان آرتریت به نوع و شدت بیماری بستگی دارد و هدف اصلی آن کاهش درد، کنترل التهاب، بهبود حرکت مفاصل و جلوگیری از آسیبهای بیشتر است. روشهای درمانی شامل داروها، روشهای فیزیکی و توانبخشی، تغییرات در سبک زندگی و در موارد شدید، جراحی است.
داروها برای کاهش درد و التهاب مفاصل استفاده میشوند. این داروها شامل داروهای ضد التهابی غیر استروئیدی (NSAIDs)، کورتیکواستروئیدها، داروهای ضد روماتیسمی تعدیلکننده بیماری (DMARDs) و بیولوژیکها هستند. هر کدام از این داروها به منظور کاهش علائم و کنترل بیماری تجویز میشوند.

روشهای فیزیکی و توانبخشی شامل تمرینات ورزشی، فیزیوتراپی و ماساژ درمانی هستند که به بهبود حرکت مفاصل و کاهش درد کمک میکنند. تمرینات ورزشی منظم و مناسب میتوانند به تقویت عضلات پیرامون مفاصل و افزایش انعطافپذیری کمک کنند.
تغییرات در سبک زندگی نیز نقش مهمی در مدیریت آرتریت دارند. کاهش وزن، تغذیه سالم، پرهیز از فعالیتهای سنگین و استفاده از تکنیکهای مدیریت استرس میتواند به بهبود وضعیت بیماران کمک کند.
جراحی در موارد شدید و پیشرفته آرتریت ممکن است لازم باشد. انواع جراحیها شامل جراحیهای تعویض مفصل، آرتروسکوپی و اصلاح استخوانی هستند. جراحیها معمولاً برای کاهش درد و بهبود عملکرد مفاصل انجام میشوند.
مراقبتهای حمایتی و روانی
آرتریت میتواند تاثیرات روانی و اجتماعی قابل توجهی بر بیماران داشته باشد. احساس درد مزمن و محدودیتهای حرکتی ممکن است باعث افسردگی، اضطراب و کاهش کیفیت زندگی شود. ارائه حمایتهای روانی و اجتماعی به بیماران میتواند به بهبود وضعیت روحی و اجتماعی آنها کمک کند.
حمایت روانی شامل مشاوره روانشناختی، گروههای حمایتی و تکنیکهای مدیریت استرس است که میتواند به کاهش اضطراب و افسردگی مرتبط با آرتریت کمک کند.
حمایت اجتماعی شامل ایجاد شبکههای حمایتی از خانواده، دوستان و گروههای اجتماعی است که میتواند به بهبود کیفیت زندگی بیماران و افزایش انگیزه و اعتماد به نفس آنها کمک کند.
پژوهش و نوآوری در درمان آرتریت
پژوهشهای جدید و نوآوریهای علمی نقش حیاتی در پیشرفتهای درمانی برای آرتریت دارند. تحقیقات جدید میتوانند به درک بهتر مکانیزمهای بیماری و توسعه روشهای نوین درمانی کمک کنند.
توسعه داروهای جدید و بیولوژیکها میتواند به بهبود نتایج درمانی برای بیماران آرتریت کمک کند. این داروها ممکن است هدفهای خاصی در سیستم ایمنی یا التهابی بدن داشته باشند و به کنترل بهتر بیماری منجر شوند.
پژوهشهای ژنتیکی میتوانند به شناسایی عوامل ژنتیکی مرتبط با آرتریت و توسعه روشهای پیشگیری و درمانی جدید کمک کنند. این تحقیقات میتوانند به درک بهتر علل بیماری و توسعه درمانهای شخصیسازی شده برای بیماران منجر شوند.
آرتریت یک بیماری مزمن و پیچیده است که میتواند تاثیرات جدی بر کیفیت زندگی افراد داشته باشد. شناخت انواع مختلف آرتریت، علائم شایع و روشهای درمانی موجود میتواند به بهبود مدیریت و درمان این بیماری کمک کند. روشهای درمانی شامل داروها، روشهای فیزیکی و توانبخشی، تغییرات در سبک زندگی و در موارد شدید، جراحی است. همچنین، حمایتهای روانی و اجتماعی نقش مهمی در بهبود کیفیت زندگی بیماران آرتریت دارد.
پژوهشهای جدید و نوآوریهای علمی میتوانند به توسعه روشهای نوین درمانی و بهبود نتایج درمانی برای بیماران آرتریت کمک کنند.
با استفاده از رویکردهای جامع و چندجانبه در مدیریت آرتریت، میتوان به بهبود وضعیت بیماران و افزایش کیفیت زندگی آنها امیدوار بود. مبارزه با آرتریت نیازمند همکاری و تلاشهای جمعی است، اما با استفاده از ابزارها و استراتژیهای موجود میتوان به نتایج مثبتی دست یافت و زندگی بسیاری از افراد را بهبود بخشید.